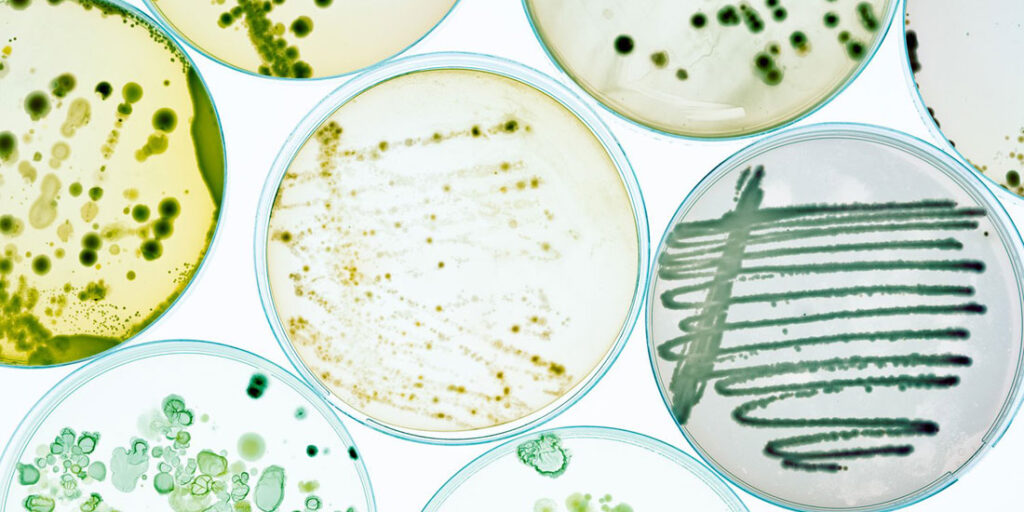

Από τον Χαράλαμπο Πετρόχειλο
Με την Ελλάδα να παραμένει πρώτη σε ολόκληρη την Ευρώπη στην κατανάλωση αντιβιοτικών για 13η συνεχόμενη χρονιά σύμφωνα με σχετική έκθεση του Ευρωπαϊκού Κέντρου Πρόληψης και Ελέγχου Νοσημάτων (ECDC) οι προτάσεις που κατέθεσαν οι φαρμακοποιοί για το ρόλο που μπορούν και πρέπει να παίξουν τα κοινοτικά φαρμακεία στην όσο το δυνατόν καλύτερη αντιμετώπιση του τεράστιου αυτού προβλήματος δημόσιας υγείας, πρέπει να ληφθούν σοβαρά υπόψιν από εκείνους που έχουν την ευθύνη για τη χάραξη πολιτικών.
Ο Πανελλήνιος Φαρμακευτικός Σύλλογος θεωρώντας ότι οι φαρμακοποιοί έχουν και μπορούν να παίξουν σημαντικό ρόλο στη μάχη κατά της μικροβιακής αντοχής πρότεινε συγκεκριμένες παρεμβάσεις με αφορμή σχετική ημερίδα – workshop που διοργάνωσε πρόσφατα το Πανεπιστήμιο Πελοποννήσου και η Ιατρική Εταιρεία Αθηνών, και όπου παρουσιάστηκε επιχειρησιακό σχέδιο για την αντιμετώπιση του εν λόγω προβλήματος.
Ο ΠΦΣ, αφού καλωσόρισε το Επιχειρησιακό σχέδιο αντιμετώπισης της μικροβιακής αντοχής Ελλάδα 2021 – 2024 δηλώνοντας έτοιμος να το στηρίξει ολόθερμα αναφέρει ότι «με τις προτάσεις μας το σχέδιό σας μπορεί να βελτιωθεί περεταίρω».
Στο πεδίο της ευαισθητοποίησης εκφράζει την άποψη πως είναι ορθό να προστεθούν δράσεις σε συνεργασία με το Υπουργείο Παιδείας σε όλα τα επίπεδα της εκπαίδευσης, ίσως επίσης και μαθήματα στα προγράμματα δημοτικού, γυμνάσιου και λυκείου. Μάλιστα σε αυτό το σημείο βλέπει πως «θα μπορούσαμε να συμβάλουμε και εμείς σε ενημερωτικές επισκέψεις στα σχολεία όλης της χώρας».
Στην ίδια λογική της ευαισθητοποίησης προτείνει επίσης τη δημιουργία εκπαιδευτικού προγράμματος για τους φαρμακοποιούς που εργάζονται στα ιδιωτικά φαρμακεία καθώς και το προσωπικό των φαρμακείων με φορέα υλοποίησης το Ινστιτούτο Δια βίου Εκπαίδευσης και Επαγγελματικής Ανάπτυξης Φαρμακοποιών και ανάλογη πιστοποίηση μετά από εξετάσεις. Η πρόταση είναι το πρόγραμμα να γίνει εξ’ αποστάσεως προκειμένου να το παρακολουθήσουν το δυνατό περισσότεροι φαρμακοποιοί και δη αυτοί των απομακρυσμένων περιοχών.
Αναφορικά με τη διενέργεια ταχέων διαδικασιών ανίχνευσης αντιγόνου και ιδίως αυτών για το στρεπτόκοκκο της ομάδας Α (strep–test Α), ο ΠΦΣ θεωρεί ότι είναι χρήσιμο να υπάρξει ενεργός συμμετοχή των φαρμακοποιών της κοινότητος καθώς η διενέργεια στα φαρμακεία σύμφωνα με τη διεθνή βιβλιογραφία φαίνεται να συμβάλει σημαντικά στη μείωση της χρήσης αντιβιοτικών.
Σχετικά επίσης με την καταγραφή των ασθενών που προσέρχονται στους ιατρούς ο ΠΦΣ θεωρεί πως θα ήταν δόκιμο να δημιουργηθεί Εθνικό Μητρώο ανάλογο αυτού των Rapid–test COVID 19 στο οποίο να καταχωρούνται τα αποτελέσματα εκ μέρους των διενεργούντων τους ελέγχους.
Μία ακόμη πρόταση του ΠΦΣ είναι η θεσμοθέτηση ετεροχρονισμένης ενεργοποίησης εκτέλεσης των αντιβιοτικών σκευασμάτων που περιλαμβάνονται σε μια συνταγή όταν το επιλέγει ο Ιατρός στη λογική ότι η μεγαλύτερη αιτία της υπερκατανάλωσης αντιβιοτικών παγκοσμίως είναι η πίεση του ασθενούς προς τον γιατρό. «Αυτό μπορεί να λυθεί σε μεγάλο βαθμό με την δημιουργία ενός μηχανισμού “καθυστερούμενης συνταγής”. Καθώς η συντριπτική πλειοψηφία των λοιμώξεων του αναπνευστικού είναι ιογενούς αιτιολογίας, η χορήγηση συνταγής με αντιβιοτικό που όμως είναι κλειδωμένη και μπορεί να εκτελεστεί τουλάχιστον 3 μέρες μετά, οδηγεί σε τεράστια μείωση της κατανάλωσης»
Ακόμη οι φαρμακοποιοί ζητούν να προστεθεί πρόβλεψη για το μεγάλο πρόβλημα της «τηλεφωνικής συνταγής». «Είναι ένα φαινόμενο η βασική αιτία του οποίου εδράζεται σε εγγενείς αδυναμίες της ΠΦΥ στη χώρα μας. Προτείνουμε να προβλεφθεί μια ηλεκτρονική εφαρμογή (ειδικού τύπου mobile application) όπου ο ιατρός, θα συνταγογραφεί μέσω αυτής της εφαρμογής ακόμη και από το κινητό του τηλέφωνο. Το κόστος της εφαρμογής μπορούν να αναλάβουν από κοινού ο ΠΦΣ με τον ΠΙΣ».
Ο ΠΦΣ προτείνει να γίνεται – σε τακτική βάση (πχ ανά 6μηνο) – ενημέρωση όλων των εμπλεκομένων προκειμένου να γίνονται οι απαραίτητες διορθώσεις και να λαμβάνονται έγκαιρα νέα μέτρα.
Αξίζει τέλος να γίνει αναφορά και στην πρόταση του ΠΦΣ σχετίζεται με την τήρηση του Εθνικού προγράμματος εμβολιασμού. Προτείνει την ενεργό συμμετοχή του κλάδου στην ενημέρωση του κοινού για την αναγκαιότητα τήρησης του Εθνικού Προγράμματος Εμβολιασμού ενηλίκων θεωρώντας ότι η δημιουργία καμπάνιας προαγωγής του Εθνικού Προγράμματος Εμβολιασμών Ενηλίκων από πλευράς φαρμακοποιών θα ήταν δόκιμη σε αυτό το πλαίσιο.